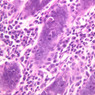
Extracted from CT_All.zip

Chapter Two: Connective Tissue
Introduction
This class of primary tissue is very appropriately named because it connects or binds all of the body's parts together. In contrast to epithelium, which is a tissue composed primarily of cells, connective tissues consist mainly of intercellular substances. Cells, though numerous, tend to be widely separated and inconspicuous among the masses of fibers and ground substance. The principal roles that these tissues play in body activities therefore are structurally expressed in the nature and densities of the intercellular fibers and ground substance. The fibers, consisting particularly of the proteins, collagen, or elastin, are responsible for the tensile strength or elasticity of the bindings. The ground substance, made up of substantially hydrated mucopolysaccharides, provides the medium through which dissolved substances pass from capillaries to cells and back. Connective tissues then, are a diverse group of tissues which have one thing in common: all consist of the same three basic elements of 1) cells, 2) fibers, and 3) ground substance or matrix. We will concentrate on connective tissue proper today. Later labs focus on cartilage, bone, blood, hematopoietic, and lymphatic tissues that are all special types of connective tissue.
Types of Connective Tissues (C.T.)
There are several different types of connective tissue. The connective tissue types are delineated by; 1) the relative proportions and types of cells present, 2) the density and nature of fibers present, and 3) the relative amount and nature of the ground substance present.
Loose Irregular Connective Tissue
Loose irregular connective tissue can be seen surrounding the epithelium in the mammary gland (slide A-93 [
2.5x,
10x,
20x-labeled,
40x] [
2.5x,
10x,
20x,
40x] [
2.5x,
10x,
20x,
40x]). Loose irregular C.T. is lightly stained by eosin and contains loosely arranged fibers and many cells.
Loose Irregular CT Image Gallery
Loose Irregular CT Table of Identifications
 Top
Top
Dense Connective Tissue
Dense connective tissue The dense connective tissues contain more numerous and thicker fibers, but considerably fewer cells. The primary cell type of the dense connective tissues is the fibroblast. This cell type is active in maintaining and synthesizing the fibers. In dense irregular C.T., the collagenous fibers are arranged in bundles without a definite orientation. In dense regular C.T. the collagenous bundles are arranged according to a definite pattern.
A. Dense irregular C.T. can be observed in the mammary gland surrounding the pockets of loose C.T (A-93 [
2.5x,
10x,
20x-labeled,
40x-labeled]). Dense C.T. stains intensely pink with eosin due to its thick collagenous fibers and the relative paucity of hematoxylin stained nuclei. The collagen fibers in dense irregular C.T. are wavy and irregular. Elastic fibers may also be present, but are masked by the density of the collagenous fibers.
B. Dense regular connective tissue is found in tendons or ligaments where the collagen fibers are all oriented in the same direction, (A-19, PTAH [
2.5x,
10x,
20x,
40x] [
10x,
20x,
40x-labeled]). Note that nuclei of cells in the tendon occur in rows between bundles of collagenous fibers. These nuclei are quite long and narrow, but are not deeply stained and, therefore, may be hard to see. The fibers that comprise the bulk of tendon tissue are parallel to the lines of force that normally act upon the living tissue. This highly ordered pattern of fibers gives tremendous tensile strength to the tendon because of the inelasticity of the collagen molecules that make up the fibers.
Dense CT Image Gallery
Dense CT Table of Identifications
| Row |
Structure |
Abbreviation |
Optimal Stain |
Representative Section |
Note |
| 1 |
Duct Epithelium |
(arrow) |
H&E |
 A93, Mammary, 20x A93, Mammary, 20x |
|
| 2 |
Capillaries |
(arrows) |
H&E |
 A93, Mammary, 20x A93, Mammary, 20x |
|
| 3 |
Collagen |
(none) |
H&E |
 A93, Mammary, 40x A93, Mammary, 40x |
|
| 4 |
Fibroblasts |
(arrows) |
H&E |
 A93, Mammary, 40x A93, Mammary, 40x |
|
| 5 |
Plasma Cell |
(arrow) |
H&E |
 A93, Mammary, 40x A93, Mammary, 40x |
|
| 6 |
Tendon Cell Nuclei |
(arrows) |
PTAH |
 A19, Tendon, 40x A19, Tendon, 40x |
|
 Top
Top
Adipose Tissue
Adipose Tissue is named for the primary cell type present, the adipocyte. In these micrographs, examine the fat cells and note the scanty rim of cytoplasm surrounding the space occupied in life by a large fat droplet, and the compressed nucleus. The fat droplets that fill the living adipose cell are dissolved away during specimen preparation. Comparable areas of extracted adipose tissue can be found in A-73 (neck, H&E [
10xlabeled,
20x,
40x-labeled] [
2.5x,
10x,
20x,
40x]). In slide A-56, the section has been stained with osmium tetroxide ([
2.5x,
10x,
20x,
40x] [
10x,
20x,
40x]). This compound stains the lipid black and prevents its extraction during tissue processing.
Adipose Image Gallery
Adipose Table of Identifications
| Row |
Structure |
Abbreviation |
Optimal Stain |
Representative Section |
Note |
| 1 |
Thyroid |
(arrow) |
H&E |
 A73, Neck, 10x A73, Neck, 10x |
|
| 2 |
Adipose Tissue |
(none) |
H&E |
 A73, Neck, 10x A73, Neck, 10x |
|
| 3 |
Skeletal Muscle |
(arrows) |
H&E |
 A73, Neck, 10x A73, Neck, 10x |
|
| 4 |
Fat Droplet |
(lines) |
H&E |
 A73, Neck, 40x A73, Neck, 40x |
|
| 5 |
Adipocyte |
(arrow) |
H&E |
 A73, Neck, 40x A73, Neck, 40x |
|
| 6 |
Adipocyte Cytoplasm |
(arrows) |
H&E |
 A73, Neck, 40x A73, Neck, 40x |
|
 Top
Top
Mucous Connective Tissue.
Mucous C.T. is a form of mesenchyme. Mesenchyme is embryonic C.T. It originates primarily from mesoderm and is characterized by numerous reticular fibers, stellate cells, which are described as being pluripotent, and an extensive amount of ground substance. Mucous C.T. is a form of mesenchyme in which the amount of ground substance is especially abundant. Slide A-95 ([
2.5x,
10x,
20x,
40x-labeled]) is a section of the umbilical cord. The mucous C.T. therein is referred to as Warton's jelly. Although much of the ground substance was extracted during preparation, that which remains, as well as the spaces, indicate that a considerable portion of this tissue is occupied by ground substance. The stain utilized is Alcian Blue. This is a cationic dye which readily binds to the negatively charged mucopolysaccharides and glycosaminoglycans of the ground substance.
Mucous CT Image Gallery
Mucous CT Table of Identifications
 Top
Top
Connective Tissue Fibers
Collagen Fibers
Collagen is a flexible but tough fiber which is found in almost every organ. By EM, it has a banding pattern which is indicative of its ordered molecular structure. Examples of collagen bundles can be seen in costal cartilage and associated tissue stained with aniline blue (where bundles stain blue) (slide A-6 [
2.5x,
10x,
20x,
40x-labeled] [
10x,
20x,
40x]), or in the H&E stained preparation of reticular dermis of the skin (slide A-58 [
2.5x,
10x,
20x,
40x] [
2.5x-labeled,
10x,
20x,
40x]). Observe that the fibers occur in wavy bundles and are acidophilic. At the EM level, collagen fibers are made up of a number of units called fibrils. Fibrils are the basic units of collagen. At the light microscopic level individual collagen fibrils cannot be discerned. Confirm that they have the following characteristics; 1) uniform diameter (for a given tissue), and 2) in CT proper they are easily identified by a characteristic 68 nm crossbanding pattern (may be unbanded in certain other tissues). This banding pattern is due to the overlap of tropocollagen molecules.
Collagen Fiber Image Gallery
Collagen Fiber Table of Identifications
| Row |
Structure |
Abbreviation |
Optimal Stain |
Representative Section |
Note |
| 1 |
Costal Cartilage |
(none) |
Aniline Blue |
 A6, Costal Cartilage, 40x A6, Costal Cartilage, 40x |
|
| 2 |
Collagen Bundles |
(none) |
Aniline Blue |
 A6, Costal Cartilage, 40x A6, Costal Cartilage, 40x |
|
| 3 |
Collagen |
(lines) |
H&E |
 A58, Skin, 2.5x A58, Skin, 2.5x |
|
| 4 |
Dermis |
(span of arrows) |
H&E |
 A58, Skin, 2.5x A58, Skin, 2.5x |
|
| 5 |
Epidermis |
(arrow) |
H&E |
 A58, Skin, 2.5x A58, Skin, 2.5x |
|
| 6 |
Sweat Gland |
(arrow) |
H&E |
 A58, Skin, 2.5x A58, Skin, 2.5x |
|
| 7 |
Sebaceous Gland |
(arrow) |
H&E |
 A58, Skin, 2.5x A58, Skin, 2.5x |
|
| 8 |
Hair Follicle |
(arrow) |
H&E |
 A58, Skin, 2.5x A58, Skin, 2.5x |
|
 Top
Top
Reticular Fibers
Reticular fibers also exhibit a 68 nm banding pattern and are the smallest of the collagen fibers. At the LM level, they stain differently from larger collagen fibers, e.g., they are agyrophilic (stain with silver) and are PAS positive (consult the glossary of stains). As a result of those differences, reticular fibers were formally thought to be a different kind of fiber from collagen. Reticular fibers are widely distributed and often form a fine scaffolding network to support cells in several organs, especially in the lymphatic system. In such locations, where reticular fibers dominate and form a 3-dimensional network for the support of other cells, the term reticular tissue is sometimes applied. Good examples of reticular tissue can be seen in lymph node (slide A-34, reticulin [
2.5x,
10x,
20x,
40x-labeled] [
10x,
20x,
40x-labeled]) and spleen (A-37, reticulin [
2.5x,
10x,
20x,
40x-labeled] [
2.5x,
10x,
20x,
40x,
40x-labeled]; H&E [
2.5x,
10x,
20x,
40x]). These are sections of lymph node and spleen which have been stained with the reticulin method, a silver impregnation technique. Find an area where cells are relatively thinned out and examine the fine, darkly-stained fibrils in such a field of view. Note their variable thickness, how they intersect, their irregular course, and in general, the meshwork they form. Reticular fibers, though composed of collagen fibrils, are readily stained with silver, whereas collagen fibers are not. In the preparation of spleen, what appear to be blackened fibers actually include processes of the parent cells of the network, appropriately known as reticular cells. The reticular cells themselves can be distinguished from other cells in the spleen only with difficulty because silver does not highlight nuclear characteristics.
Reticular Fiber Image Gallery
Reticular Fiber Table of Identifications
 Top
Top
Elastic Fibers
Elastic fibers are comprised of elastin and consist of branching threads that are generally thinner than collagen fibers. In the fresh state, they are yellow. In routine LM preparations (H&E), they are refractile bands or threads, but are often difficult to visualize. They can, however, be demonstrated when special stains are employed (e.g., orcein, resorcin-fuschin).
If an organ or tissue is subject to internal/external forces, but should not deform for proper function to be retained, the organ would need resilience. A good example is blood vessels. You can see elastic fibers in the aorta (slide A-27, Verhoeff [
2.5x,
10x,
20x,
40x-labeled] [
2.5x-labeled,
10x,
20x,
40x,
40x-labeled]) where they will appear as black strands in the blood vessel wall. Elastic fibers in large aggregates occur in fewer places than dense collections of collagenous fibers. Nevertheless, sheets of elastin are prominent elements of arterial walls, and are especially well represented in the aorta. The elastic tissue in an H&E section of this vessel appears as refractile or shiny pink bands of tissue. Note the placement of cell nuclei which belong to smooth muscle cells. These fibers are synthesized by fibroblasts and smooth muscle cells in the wall of the blood vessel. At the EM level, elastic fibers have two components; 1) elastin and 2) microfibrils.
Elastic Fiber Image Gallery
Elastic Fiber Table of Identifications
| Row |
Structure |
Abbreviation |
Optimal Stain |
Representative Section |
Note |
| 1 |
Large Elastic Artery |
(none) |
Verhoeff |
 A27, Aorta, 2.5x A27, Aorta, 2.5x |
|
| 2 |
Tunica Intima |
(arrow) |
Verhoeff |
 A27, Aorta, 2.5x A27, Aorta, 2.5x |
|
| 3 |
Tunica Media |
(none) |
Verhoeff |
 A27, Aorta, 2.5x A27, Aorta, 2.5x |
|
| 4 |
Tunica Adventitia |
(none) |
Verhoeff |
 A27, Aorta, 2.5x A27, Aorta, 2.5x |
|
| 5 |
Fibroblast |
F |
Verhoeff |
 A27, Aorta, 40x A27, Aorta, 40x |
|
| 6 |
Nuclei of Smooth Muscle Cells |
(arrows) |
Verhoeff |
 A27, Aorta, 40x A27, Aorta, 40x |
|
| 7 |
Elastic Fibers |
(arrows) |
Verhoeff |
 A27, Aorta, 40x A27, Aorta, 40x |
|
 Top
Top
Matrix
The concept of a "ground substance" or a pervasive gel-like substance found in all of the connective tissues is a difficult concept. One preparation in your class sets (slide A-95, Alcian blue-PAS [
2.5x,
10x,
20x,
40x-labeled]; H&E [
2.5x,
10x,
20x,
40xlabeled]), specifically the umbilical cord stained with Alcian blue, documents the presence of mucous-connective tissue where the predominant element of the connective tissue is ground substance. The alcian blue has affinity for the sulfate side groups of the glycosaminoglycans. The spaces that appear empty in H&E are filled in the corresponding sections stained with alcian blue.
The consistency of ground substance is very viscous or gel-like. This is due to the degree of hydration of the glycosaminoglycans. One aspect of this is that it limits the spread of particles (e.g., bacteria; some bacteria known to spread rapidly in C.T. contain the enzyme hyaluronidase).
Matrix Image Gallery
Matrix Table of Identifications
 Top
Top
Cells
The cells in connective tissue proper can be either fixed (remain in the CT) or wandering (can enter and leave the CT, usually via the blood stream).
Fixed Cells
Fibroblasts
Fibroblasts (fibrocytes) are the most common fixed cells in connective tissues. Examine slide A-19 (myotendinous junction, PTAH [
10x,
20x,
40x-labeled,
40x,
40x]). Elongated purplish nuclei oriented parallel to the collagen bundles are present within the tendon. These are the nuclei of fibroblasts. Fibroblasts, which comprise the majority of connective tissue cells, are characterized by long cytoplasmic processes that pass between collagen bundles. This is not always apparent at the light microscopic level. Fibroblasts are extremely important cells as they produce the extracellular matrix of connective tissue. Is this cell surrounded by a basal lamina?
Fibroblast Image Gallery
Fibroblast Table of Identifications
 Top
Top
Adipose Cells
Adipose Cells (fat cells) are large and round with a large lipid droplet in the cell. If the lipid has been removed in histologic processing, only a thin rim of cytoplasm will be present, e.g., pink circles in profile. See the hypodermis of Slides A-48 ([
2.5xlabeled,
10x,
20x,
40x-labeled]), A-50 ([
2.5x,
10x,
20x,
40x]), A-52 ([
10x,
20x,
40x]), and A-58 ([
2.5x,
10x,
20x]). If the lipid has been stabilized (by a lipid fixative like osmium), the fat cells appear as large black spheres (slide A-56 [
2.5x,
10x,
20x] [
2.5x,
10x,
20x]).
Adipocyte Image Gallery
Adipocyte Table of Identifications
| Row |
Structure |
Abbreviation |
Optimal Stain |
Representative Section |
Note |
| 1 |
Hypodermis |
(none) |
H&E |
 A48, Hypodermis, 2x A48, Hypodermis, 2x |
|
| 2 |
Dermis Collagen |
(none) |
H&E |
 A48, Hypodermis, 2x A48, Hypodermis, 2x |
|
| 3 |
Blood Vessel |
BV |
H&E |
 A48, Hypodermis, 2x A48, Hypodermis, 2x |
|
| 4 |
Sebaceous Gland |
S |
H&E |
 A48, Hypodermis, 2x A48, Hypodermis, 2x |
|
| 5 |
Sweat Gland |
Sg |
H&E |
 A48, Hypodermis, 2x A48, Hypodermis, 2x |
|
| 6 |
Adipoctye |
(arrow) |
H&E |
 A48, Hypodermis, 2x A48, Hypodermis, 2x |
|
| 7 |
Adipoctye Lipid Droplet |
(none) |
H&E |
 A48, Hypodermis, 40x A48, Hypodermis, 40x |
|
| 8 |
Adipoctye Cytoplasm |
(arrow) |
H&E |
 A48, Hypodermis, 40x A48, Hypodermis, 40x |
|
| 9 |
Nuclei |
(arrows) |
H&E |
 A48, Hypodermis, 40x A48, Hypodermis, 40x |
|
| 10 |
Lymphocyte |
(arrow) |
H&E |
 A48, Hypodermis, 40x A48, Hypodermis, 40x |
|
| 11 |
Blood Vessel |
(arrow) |
H&E |
 A48, Hypodermis, 40x A48, Hypodermis, 40x |
|
 Top
Top
Macrophages
Macrophages (or Histiocytes). Fixed macrophages are difficult to distinguish from fibroblasts by light microscopy. Macrophages phagocytose material (slide B-12 [
2.5x,
10x,
20x,
40x-labeled]). Since they are the scavengers of the connective tissue, they play an important role in the tissue defense.
Macrophage Image Gallery
Macrophage Table of Identifications
 Top
Top
Mast Cells
Mast Cells, which are similar to blood basophils, contain basophilic granules, representing heparin, histamine, and serotonin. Mast cells are easily discernible in the connective tissue spread on slide A-8 (omentum, Resorcin-Fuchsin [
10x,
20x,
40x,
40x]). The mast cells are distinguished by their content of purple granules.
Mast Cell Image Gallery
Mast Cell Table of Identifications
 Top
Top
Plasma Cells
Plasma Cells are derived from lymphocytes and produce antibodies. They will be dealt with in the section on lymphatic tissue. At the LM level, two aspects of plasma cell structure, when discernible, cause them to be distinctive. First, the nucleus is often eccentric in the cytoplasm and the cytoplasm displays a clear area ("negative" Golgi image). The second aspect is that the heterochromatin in plasma cell nuclei is often arranged in such a fashion that it is said to be in a "cartwheel" image; e.g., areas of heterochromatin alternate with areas of euchromatin in such a way that lightly staining areas radiate outward from the center of the nucleus. Plasma cells are fairly common in the loose C.T. below the intestinal epithelium known as the lamina propria. Examine this area in slide B-12 (jejunum, H&E [
2.5x-labeled,
10x-labeled,
20x,
40x,
40x-labeled] [
2.5x,
10x,
20x,
40x-labeled,
40x]) or B-15 (jejunum, H&E [
20x,
40x-labeled,
40x]) and attempt to locate one. Because of the large amounts of rough ER they tend to be basophilic (and large). What aspects would suggest the plasma cell is active in protein synthesis?
Plasma Cell Image Gallery
Plasma Cell Table of Identifications
| Row |
Structure |
Abbreviation |
Optimal Stain |
Representative Section |
Note |
| 1 |
Muscularis Externa |
(span of arrows) |
H&E |
 B12, Jejunum, 2.5x B12, Jejunum, 2.5x |
|
| 2 |
Submucosa |
(span of arrows) |
H&E |
 B12, Jejunum, 2.5x B12, Jejunum, 2.5x |
|
| 3 |
Mucosa |
(span of arrows) |
H&E |
 B12, Jejunum, 2.5x B12, Jejunum, 2.5x |
|
| 4 |
Lamina Propria |
LP |
H&E |
 B12, Jejunum, 10x B12, Jejunum, 10x |
|
| 5 |
Intestinal Gland |
IG |
H&E |
 B12, Jejunum, 40x B12, Jejunum, 40x |
|
| 6 |
Mitotic Figure |
MF |
H&E |
 B12, Jejunum, 40x B12, Jejunum, 40x |
|
| 7 |
Plasma Cell |
PC |
H&E |
 B12, Jejunum, 40x B12, Jejunum, 40x |
|
| 8 |
Blood Vessel |
BV |
H&E |
 B12, Jejunum, 40x B12, Jejunum, 40x |
|
| 9 |
Lymphocyte |
L |
H&E |
 B12, Jejunum, 40x B12, Jejunum, 40x |
|
| 10 |
Eosinophil |
E |
H&E |
 B12, Jejunum, 40x B12, Jejunum, 40x |
|
 Top
Top
Wandering Cells
Almost any circulating blood cell may be found, transiently, in C.T. Examine the connective tissue beneath the epithelium (lamina propria) in slide B-16 (ileum, H&E [
2.5x,
10x,
20x,
40x,
40x] [
40x,
40x,
40x,
40x,
40x,
40x]) and attempt to identify the following cell types.
Monocytes
These can exit the blood stream and enter connective tissue to become a phagocyte. In comparison to the ultrastructure of a phagocyte, a macrophage displays many finger-like projections of its plasma membrane. What is the functional significance of these?
Lymphocytes
Lymphocytes are small cells, generally 7.5μm in diameter and with a very thin rim of bluish cytoplasm surrounding the nucleus. The nucleus is round or slightly indented, contains a rather granular chromatin, and fills most of the cell. Ultrastructurally, these cells have granular cytoplasm with many ribosomes.
Eosinophils
Eosinophils are less frequently observed. This cell is characterized by a deeply basophilic nucleus, but with only 2-3 lobes. Coarse orange-to-red granules fill much of the cytoplasm, which measures 10-15μ in diameter. Eosinophils are active in the phagocytosis of molecular antigen-antibody complexes and thus their granules also represent lysosomes.
Wandering Cell Image Gallery
 Top
Top
Review of Chapter Two
Review of Slides
Review of Identifications
| Row |
Structure |
Abbreviation |
Optimal Stain |
Representative Section |
Note |
| 1 |
Loose Irregular Connective Tissue |
LCT |
H&E |
 A93, Mammary, 20x A93, Mammary, 20x |
|
| 2 |
Dense Irregular Connective Tissue |
DCT |
H&E |
 A93, Mammary, 20x A93, Mammary, 20x |
|
| 3 |
Duct Epithelium |
(arrow) |
H&E |
 A93, Mammary, 20x A93, Mammary, 20x |
|
| 4 |
Capillaries |
(arrows) |
H&E |
 A93, Mammary, 20x A93, Mammary, 20x |
|
| 5 |
Collagen |
(none) |
H&E, PTAH |
 A93, Mammary, 40x; A93, Mammary, 40x;  A6, Costal Cartilage, 40x; A6, Costal Cartilage, 40x;  A58, Skin, 2.5x; A58, Skin, 2.5x;  A19, Myotendinous Junction, 40x A19, Myotendinous Junction, 40x |
|
| 6 |
Fibroblasts |
F, (arrows) |
H&E, PTAH |
 A93, Mammary, 40x; A93, Mammary, 40x;  A27, Aorta, 40x; A27, Aorta, 40x;  A95, Umbilical Cord, 40x; A95, Umbilical Cord, 40x;  A19, Myotendinous Junction, 40x A19, Myotendinous Junction, 40x |
|
| 7 |
Plasma Cell |
(arrow) |
H&E |
 A93, Mammary, 40x A93, Mammary, 40x |
|
| 8 |
Tendon Cell Nuclei |
(arrows) |
PTAH |
 A19, Tendon, 40x A19, Tendon, 40x |
|
| 9 |
Thyroid |
(arrow) |
H&E |
 A73, Neck, 10x A73, Neck, 10x |
|
| 10 |
Adipose Tissue |
(none) |
H&E |
 A73, Neck, 10x A73, Neck, 10x |
|
| 11 |
Skeletal Muscle |
(arrows) |
H&E |
 A73, Neck, 10x A73, Neck, 10x |
|
| 12 |
Fat Droplet |
(lines) |
H&E |
 A73, Neck, 40x A73, Neck, 40x |
|
| 13 |
Adipocyte |
(arrow) |
H&E |
 A73, Neck, 40x; A73, Neck, 40x;  A48, Hypodermis, 2x A48, Hypodermis, 2x |
|
| 14 |
Adipocyte Cytoplasm |
(arrows) |
H&E |
 A73, Neck, 40x A73, Neck, 40x |
|
| 15 |
Mucous Connective Tissue (AKA Warton's jelly) |
MCT, (none) |
Alcian Blue |
 A95, Umbilical Cord, 40x; A95, Umbilical Cord, 40x;  A95, Umbilical Cord, 40x A95, Umbilical Cord, 40x |
|
| 16 |
Ground Substance |
(lines) |
Alcian Blue |
 A95, Umbilical Cord, 40x A95, Umbilical Cord, 40x |
|
| 17 |
Stellate Cells |
(arrows) |
Alcian Blue |
 A95, Umbilical Cord, 40x A95, Umbilical Cord, 40x |
|
| 18 |
Costal Cartilage |
(none) |
Aniline Blue |
 A6, Costal Cartilage, 40x A6, Costal Cartilage, 40x |
|
| 19 |
Dermis |
(span of arrows) |
H&E |
 A58, Skin, 2.5x A58, Skin, 2.5x |
|
| 20 |
Epidermis |
(arrow) |
H&E |
 A58, Skin, 2.5x A58, Skin, 2.5x |
|
| 21 |
Sweat Gland |
(arrow) |
H&E |
 A58, Skin, 2.5x A58, Skin, 2.5x |
|
| 22 |
Sebaceous Gland |
(arrow) |
H&E |
 A58, Skin, 2.5x A58, Skin, 2.5x |
|
| 23 |
Hair Follicle |
(arrow) |
H&E |
 A58, Skin, 2.5x A58, Skin, 2.5x |
|
| 24 |
Reticular Fibers |
RF |
Reticulin |
 A34, Lymph Node, 40x; A34, Lymph Node, 40x;  A37, Spleen, 40x A37, Spleen, 40x |
|
| 25 |
Reticular Cell |
RC |
Reticulin |
 A34, Lymph Node, 40x A34, Lymph Node, 40x |
|
| 26 |
Lymphocyte |
L |
Reticulin, H&E |
 A34, Lymph Node, 40x; A34, Lymph Node, 40x;  A48, Hypodermis, 40x A48, Hypodermis, 40x |
|
| 27 |
Large Elastic Artery |
(none) |
Verhoeff |
 A27, Aorta, 2.5x A27, Aorta, 2.5x |
|
| 28 |
Tunica Intima |
(arrow) |
Verhoeff |
 A27, Aorta, 2.5x A27, Aorta, 2.5x |
|
| 29 |
Tunica Media |
(none) |
Verhoeff |
 A27, Aorta, 2.5x A27, Aorta, 2.5x |
|
| 30 |
Tunica Adventitia |
(none) |
Verhoeff |
 A27, Aorta, 2.5x A27, Aorta, 2.5x |
|
| 31 |
Nuclei of Smooth Muscle Cells |
(arrows) |
Verhoeff |
 A27, Aorta, 40x A27, Aorta, 40x |
|
| 32 |
Elastic Fibers |
(arrows) |
Verhoeff |
 A27, Aorta, 40x A27, Aorta, 40x |
|
| 33 |
Dense Regular Connective Tissue |
(none) |
PTAH |
 A19, Myotendinous Junction, 40x A19, Myotendinous Junction, 40x |
|
| 34 |
Hypodermis |
(none) |
H&E |
 A48, Hypodermis, 2x A48, Hypodermis, 2x |
|
| 35 |
Adipoctye Lipid Droplet |
(none) |
H&E |
 A48, Hypodermis, 40x A48, Hypodermis, 40x |
|
| 36 |
Adipocyte Nuclei |
(arrows) |
H&E |
 A48, Hypodermis, 40x A48, Hypodermis, 40x |
|
| 37 |
Blood Vessel |
(arrow) |
H&E |
 A48, Hypodermis, 40x A48, Hypodermis, 40x |
|
| 38 |
Simple Columnar Epithelium |
(none) |
H&E |
 B12, Jejunum, 40x B12, Jejunum, 40x |
|
| 39 |
Macrophage |
(arrow) |
H&E |
 B12, Jejunum, 40x B12, Jejunum, 40x |
|
| 40 |
Mast Cell |
(purple cells) |
Resorcin-Fuchsin |
 A8, Omentum, 40x A8, Omentum, 40x |
|
| 41 |
Muscularis Externa |
(span of arrows) |
H&E |
 B12, Jejunum, 2.5x B12, Jejunum, 2.5x |
|
| 42 |
Submucosa |
(span of arrows) |
H&E |
 B12, Jejunum, 2.5x B12, Jejunum, 2.5x |
|
| 43 |
Mucosa |
(span of arrows) |
H&E |
 B12, Jejunum, 2.5x B12, Jejunum, 2.5x |
|
| 44 |
Lamina Propria |
LP |
H&E |
 B12, Jejunum, 10x B12, Jejunum, 10x |
|
| 45 |
Intestinal Gland |
IG |
H&E |
 B12, Jejunum, 40x B12, Jejunum, 40x |
|
| 46 |
Mitotic Figure |
MF |
H&E |
 B12, Jejunum, 40x B12, Jejunum, 40x |
|
| 47 |
Plasma Cell |
PC |
H&E |
 B12, Jejunum, 40x B12, Jejunum, 40x |
|
| 48 |
Eosinophil |
E |
H&E |
 B12, Jejunum, 40x B12, Jejunum, 40x |
|
 Top
Top
--
AshleyLPistorio - 27 May 2007
 Copyright © by the contributing authors. All material on this collaboration platform is the property of the contributing authors.
Copyright © by the contributing authors. All material on this collaboration platform is the property of the contributing authors.